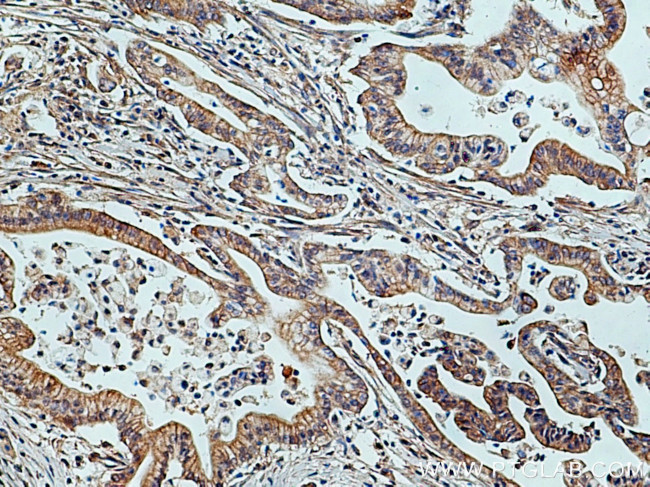
TRIM26 Antibody in Immunohistochemistry (Paraffin) (IHC (P))

Search
Proteintech
TRIM26 Polyclonal Antibody
{{$productOrderCtrl.translations['antibody.pdp.commerceCard.promotion.promotions']}}
{{$productOrderCtrl.translations['antibody.pdp.commerceCard.promotion.viewpromo']}}
{{$productOrderCtrl.translations['antibody.pdp.commerceCard.promotion.promocode']}}: {{promo.promoCode}} {{promo.promoTitle}} {{promo.promoDescription}}. {{$productOrderCtrl.translations['antibody.pdp.commerceCard.promotion.learnmore']}}
产品信息
27013-1-AP
种属反应
宿主/亚型
分类
类型
抗原
偶联物
形式
浓度
规格
纯化类型
保存液
内含物
保存条件
运输条件
产品详细信息
Immunogen sequence: NHLSTLRRD RDKIQGFQAK GEADILAALK KLQDQRQYIV AEFEQGHQFL REREEHLLEQ LAKLEQELTE GREKFKSRGV GELARLALVI SELEGKAQQP AAELMQDTRD FLNRYPRKKF W (151-270 aa encoded by BC024039)
靶标信息
TRIM26 is a member of the tripartite motif (TRIM) family. The TRIM motif includes three zinc-binding domains, a RING, a B-box type 1 and a B-box type 2, and a coiled-coil region. The protein localizes to cytoplasmic bodies. Although the function of the protein is unknown, the RING domain suggests that the protein may have DNA-binding activity. The protein encoded by this gene is a member of the tripartite motif (TRIM) family. The TRIM motif includes three zinc-binding domains, a RING, a B-box type 1 and a B-box type 2, and a coiled-coil region. The protein localizes to cytoplasmic bodies. Although the function of the protein is unknown, the RING domain suggests that the protein may have DNA-binding activity. The gene localizes to the major histocompatibility complex (MHC) class I region on chromosome 6.
仅用于科研。不用于诊断过程。未经明确授权不得转售。
生物信息学
蛋白别名: Acid finger protein; AFP; RING finger protein 95; tripartite motif protein 26; tripartite motif protein TRIM26; Tripartite motif-containing protein 26; widely expressed acid zinc finger protein; Zinc finger protein 173
基因别名: AFP; AI462198; RNF95; TRIM26; Zfp173; Zfp1736; ZNF173
UniProt ID: (Human) Q12899, (Mouse) Q99PN3
Entrez Gene ID: (Human) 7726, (Mouse) 22670